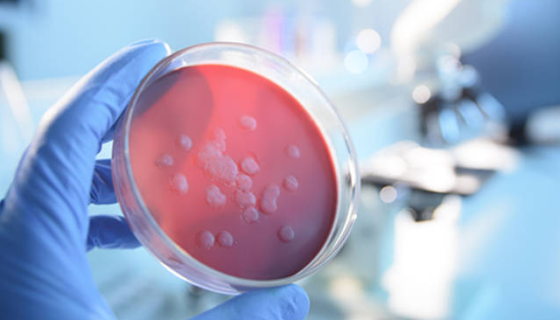
对药品微生物检验所用培养基的研究！

成骨细胞分化培养基的背景与应用及相关研究!
成骨细胞分化培养基是专门为正常人类成骨细胞体外培养设计的最适...

人口腔角质细胞的背景与应用及研究动态!
人口腔角质细胞提取于人口腔黏膜组织,原代冻存。通过Cytok...

NCI-H128人小细胞肺癌细胞的性质用途与生产工艺!
人小细胞肺癌细胞是一种典型的小细胞性肺癌细胞,表达较高水平的...

人角膜上皮细胞系的主要功能与体外培养及其应用!
人角膜上皮细胞分离自眼角膜组织;角膜系眼球外膜呈半球形向前突...

瓜果腐霉的形态特征与主要分布及真菌特点!
瓜果腐霉,腐霉科腐霉属真菌。瓜果腐霉是微生物名词,菌落在CM...

粘着剑菌——用于植物冠瘿病害和遗传转化材料
粘着剑菌是Ensifer属的微生物,原产地为中国。主要用途为...

猫星形脑胶质细胞的培养操作步骤及注意事项!
猫星形脑胶质细胞,用于可复制逆转录病毒检测。对鼠病毒、猫毒、...
对药品微生物检验所用培养基的研究!
药品微生物检验是我国药品生产部门十分重视的一项内容,只有准确...

成团肠杆菌的形态特征与功能特点及主要价值!
成团肠杆菌是Enterobacter属的微生物,原产地为中国...